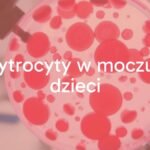
A microscope view of red blood cells in a urine sample, medical setting, clean and professional lighting, realistic.

Bajka na dobranoc to znacznie więcej niż tylko historia przeczytana przed snem. To wyjątkowy zwyczaj, który od pokoleń pomaga dzieciom na całym świecie spokojnie zasnąć. To chwila wyciszenia, bliskości z rodzicem i pozytywnych wspomnień. Wieczór to czas zwalniania tempa, kiedy dzieci szykują się do snu. W wielu domach bajka na dobranoc to ulubiony punkt wieczoru – nieodłączny element codziennej rutyny.
Bajki na dobranoc chociaż są krótkie i proste, robią duże wrażenie. Pozwalają dzieciom przenieść się do krainy wyobraźni, pełnej różnych przygód. Takie historie wyciszają, uczą wartości i pomagają dziecku spokojnie zakończyć dzień. Wieczorne czytanie to czas, gdy opiekun zbliża się do dziecka, a ciepły głos tworzy poczucie bezpieczeństwa i zaufania.

Cechy charakterystyczne bajek na dobranoc
Bajki na dobranoc mają kilka ważnych cech:
- Uspokajająca treść: Są napisane tak, aby pomóc dziecku się wyciszyć. Mają spokojnych bohaterów, delikatną narrację, dobre zakończenia, brak nagłych zwrotów akcji czy strasznych stworzeń.
- Powtarzalność: Dzieci chętnie słuchają tych samych opowieści wiele razy. Powtarzanie daje im poczucie bezpieczeństwa, pozwala aktywnie uczestniczyć w czytaniu i pomaga zapamiętywać słowa oraz fabułę.
- Nauka wartości: Bajki przekazują ważne zasady – jak dobroć, przyjaźń, odwaga, uczciwość – zwykle prostym i łatwym do zrozumienia językiem.
Skąd wynika popularność bajek przed snem?
Bajki na dobranoc mają powodzenie z wielu powodów:
- Budują wieczorną rutynę – dzieci lepiej zasypiają, jeśli ich wieczory są przewidywalne.
- To czas na wzmocnienie więzi rodzinnych – parę minut razem z rodzicem uspokaja i pomaga w budowaniu relacji.
- Czytanie bajek rozwija język, rozumienie i wyobraźnię, a to procentuje w dalszym życiu.
Jak bajka na dobranoc pomaga dziecku?
Bajki przed snem mają wiele plusów dla rozwoju dziecka:
- Ułatwiają zasypianie i przynoszą spokój.
- Wzmacniają więzi rodzinne i poczucie bezpieczeństwa.
- Rozwijają wyobraźnię, język i kreatywność.
- Pomagają lepiej zrozumieć emocje i radzić sobie ze stresem.
Jak bajka wycisza i daje spokojny sen?
Po dniu pełnym wrażeń dzieciom trudno jest się uspokoić. Bajka na dobranoc pomaga im się wyciszyć, bo tworzy spokojną atmosferę. Spokojna fabuła (np. liczenie gwiazd czy chodzenie po chmurkach) pomaga się zrelaksować i lepiej zasnąć. Dziecko dzięki rutynie wie, czego się spodziewać i łatwiej odgania lęki związane z ciemnością czy samotnością.
Jak czytanie bajek buduje więzi?
Czytanie bajek wspólnie z dzieckiem to świetny sposób, by być blisko. Rodzic jest wtedy tylko dla dziecka, a ono czuje się ważne i kochane. Dzięki temu buduje się pewność siebie i zdrowe emocje. Rozmowy o przygodach bohaterów są okazją do dzielenia się własnymi przemyśleniami i przeżyciami.
W jaki sposób bajki rozwijają wyobraźnię i język?
Bajki pomagają rozwijać wyobraźnię, bo dzieci same muszą sobie wyobrazić świat przedstawiony w książce. Dzięki temu uczą się kreatywności, nowych słów i poprawnej mowy. Bajki pokazują też, jak budować spójną opowieść i rozumieć przyczyny oraz skutki różnych wydarzeń.

Czy bajki pomagają w nauce wartości i emocji?
Bajki pokazują świat pozytywnych wartości w prosty sposób. Bohaterowie pokazują, jak być odważnym, pomagać innym i radzić sobie z uczuciami. Dziecko, identyfikując się z bohaterami, uczy się empatii, współczucia i rozwoju emocjonalnego.
Jak wybrać bajkę na dobranoc?
Dobra bajka na dobranoc powinna być dostosowana do wieku, charakteru i potrzeb dziecka. Powinna być spokojna, nie za długa i napisana prostym językiem. Przy wyborze bajki warto wziąć pod uwagę zainteresowania malucha oraz specyficzne sytuacje, które są dla niego ważne.
Na co zwracać uwagę wybierając bajkę?
- Treść powinna być łagodna i nie wzbudzająca lęku.
- Język – prosty, ale rozbudowany, może wprowadzać nowe słowa.
- Ilustracje – kolorowe, przyjemne i wspierające wyobraźnię.
- Nastrój – opowieść powinna wyciszać, napawać nadzieją i spokojem.
Czy długość bajki jest ważna?
Tak, szczególnie dla młodszych dzieci. Krótsze bajki są lepsze – dziecko łatwiej utrzyma uwagę. Starszym można czytać nieco dłuższe historie, ale najważniejsze to obserwować reakcję dziecka i dopasować długość opowieści do jego możliwości.
Jak dopasować temat bajki do wieku?
- Dla najmłodszych: proste rymowanki, bajki o zwierzętach, powtarzalne schematy.
- Dla przedszkolaków (3-5 lat): nieco dłuższe historie o przyjaźni czy emocjach, bajki o znanych sytuacjach z codzienności.
- Dla starszych dzieci (5+): klasyczne baśnie, opowieści o księżniczkach, rycerzach, dinozaurach lub zgodne z aktualnymi zainteresowaniami dziecka.

Najpopularniejsze rodzaje bajek na dobranoc
Bajki na dobranoc są bardzo różnorodne, dlatego łatwo dobrać coś odpowiedniego dla każdego dziecka. Oto kilka rodzajów:
| Rodzaj | Przykłady | Korzyści |
|---|---|---|
| Klasyczne bajki i baśnie | “Brzydkie kaczątko”, “Pinokio”, “Kot w butach” | Uczą tradycyjnych wartości, pobudzają wyobraźnię |
| Bajki pomagające (terapeutyczne) | “Które drzwi wybierasz?”, “Cicha myszka” | Pomagają radzić sobie z emocjami, tłumaczą trudne uczucia |
| Historie o zwierzętach i przyjaciołach | “Przygody niedźwiadków”, “Królik, który miał głośne myśli” | Uczą współpracy, empatii i przyjaźni |
| Bajki relaksacyjne | “Jeżyk Cyprian liczy gwiazdy” | Pomagają dziecku wyciszyć się przed snem |
Przykłady bajek na dobranoc
Poniżej kilka bajek, które sprawdzają się przed snem:
- Przygody jeżyka Cypriana: np. “Jeżyk Cyprian liczy gwiazdy” – pomaga dziecku wyciszyć się przy liczeniu gwiazd.
- Bajki o misiach: opowieści o przygodach niedźwiadków w lesie.
- Bajki o króliczku szukającym przyjaciela: uczy, jak budować przyjaźnie i być otwartym na innych.
- Opowieści o księżniczce i wróżce: rozwijają wyobraźnię i pokazują, czym jest dobro i odwaga.
Praktyczne porady dla rodziców
Jak najlepiej przygotować się do czytania bajki na dobranoc?
- Stwórz spokojną atmosferę – przygaś światła, wyłącz telewizor, przygotuj wygodne poduszki i kocyk.
- Unikaj pośpiechu i skup się na dziecku.
- Zaangażuj dziecko – pozwól zadawać pytania, opowiadać o ilustracjach, naśladować bohaterów.
- Cierpliwość – jeśli dziecko się wierci, dostosuj bajkę do jego potrzeb, wybierz krótszą historię lub czytaj w ruchu.

Czy warto czytać te same bajki wiele razy?
Tak! Dzieci uwielbiają wracać do ulubionych bajek. Powtarzanie daje im pewność, pozwala lepiej rozumieć treść, ćwiczyć pamięć i wprowadza regularność w wieczorne rytuały.
Najczęściej zadawane pytania dotyczące bajek na dobranoc
- Od kiedy można czytać dziecku bajki?
Warto zacząć jak najwcześniej, nawet niemowlęta słuchają głosu rodzica. Rytm, intonacja i wspólne spędzanie czasu budują bliskość. - Czy bajki pomagają wyciszyć emocje?
Tak, dzięki spokojnej treści i obecności rodzica bajka pomaga rozładować napięcie po całym dniu. - Jakie są najpopularniejsze polskie bajki na dobranoc?
Należą do nich m.in.: “Kwiat paproci”, “Smok Wawelski”, “Bazyliszek”, a także współczesne historie o zwierzętach czy codziennych przygodach dzieci.
Bajki na dobranoc – podsumowanie
Bajka na dobranoc to nie tylko sympatyczny zwyczaj. To ważny element codziennego życia, pomagający w rozwoju dziecka na wielu poziomach. Wieczorne czytanie buduje wyobraźnię, wzmacnia więź z rodzicem i pozwala dziecku spokojnie wejść w świat snu. To najlepszy sposób na zakończenie dnia – kilka minut z książką, spokojny głos rodzica, poczucie bliskości i radość z bycia razem. Warto budować ten nawyk każdego dnia, bo to procentuje na długie lata.

Zostaw komentarz